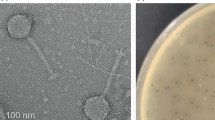

Abstract
Ninety-six isolates of Klebsiella pneumoniae and K. oxytoca were recovered from wild mammals in Australia. 14.6% of these bacteria produce killing phenotypes that suggest the production of bacteriocin toxins. Cloning and sequencing of the gene clusters encoding two of these killing phenotypes revealed two instances of a bacteriocin associated with a bacteriophage gene, the first such genetic organization described. The newly identified klebicin C gene cluster was discovered in both K. pneumoniae and K. oxytoca. The newly identified klebicin D gene cluster was detected in K. oxytoca. Protein sequence comparisons and phylogenetic inference suggest that klebicin C is most closely related to the rRNase group of colicins (such as colicin E4), while klebicin D is most closely related to the tRNase group of colicins (such as colicin D). The klebicin C and D gene clusters have similar genetic and regulatory organizations. In both cases, an operon structure is inferred consisting of a phage-associated open reading frame and klebicin activity and associated immunity genes. This novel bacteriophage/bacteriocin organization may provide a novel mechanism for the generation of bacteriocin diversity in Klebsiella.
Similar content being viewed by others
Avoid common mistakes on your manuscript.
Introduction
Bacteriocins are a diverse family of protein toxins produced by bacteria, which kill or inhibit members of the same or closely related species (Tagg et al. 1976). The bacteriocins produced by E. coli, the colicins, were the first to be identified and have since served as a model system for investigations of bacteriocin structure and function, genetic organization, ecology and evolution (Braun et al. 1994; Riley 1993a,b, 1998; Riley and Wertz 2002; Roos et al. 1989; Tan and Riley 1997).
All colicins studied to date exhibit a unique, three-domain structure. The receptor-binding domain recognizes and binds to specific cell surface receptors on the target cells. The N-terminal translocation domain interacts with cell membrane proteins to gain access to the cell interior. The C-terminal domain specifies a killing activity, such as pore formation or nuclease activity. An immunity protein protects the producing cell by binding to the killing domain of the colicin protein. A lysis protein is often associated with colicin production and plays a role in the release of colicin from the producing cell (Pugsley and Schwartz 1983a,b).
Studies comparing colicin toxins and the genes associated with their production have proven useful in inferring the evolutionary mechanisms that contribute to the existing diversity of bacteriocins (Riley 1993a, 1998; Riley and Wertz 2002; Tan and Riley 1997). Such studies suggest that bacteriocins experience the powerful force of diversifying selection that continuously sifts through novel toxin variants created by recombination and mutation. An extraordinary array of colicins and their associated immunity proteins have resulted from these processes, making them a useful model for studying the evolution of protein diversity at the molecular level.
Colicins have served as the primary model for research on bacteriocin molecular evolution. Only recently have bacteriocins of other enteric bacteria been examined (Riley et al. 2001; Wertz and Riley 2004), such as cloacins of Enterobacter cloacae (Tieze et al. 1969), klebicins of Klebsiella species (James et al. 1987; Riley et al. 2001), alveicins of Hafnia alvei (Wertz and Riley 2004), marcescins of Serratia marcescens (Guasch et al. 1995; Nasu 1981; Traub et al. 1971; Viejo et al. 1992), and pesticins of Yersinia pestis (Rakin et al. 1996). However, as yet we know little about how this diversity of enteric toxins arose, diversified and is maintained in microbial populations.
In the present study the bacteriocin-encoding DNA of two klebicin-producing isolates of Klebsiella were cloned and their nucleotide sequences determined to further examine the evolutionary relationships between klebicins and other colicin and colicin-like toxins. DNA and protein sequence analysis reveals that these klebicins are the result of numerous recombination events generating novel combinations of receptor binding, translocation and killing domains. Further, these klebicins are the first bacteriocins found in close association with bacteriophage genes. This association suggests that Klebsiella has evolved a novel mechanism for the lateral transfer and diversification of its klebicins.
Materials and Methods
Microbial Strains and Media
The Klebsiella strains used in this study are from the Australian Enteric Collection, which comprises environmental enteric bacteria isolated from wild mammals in Australia (Gordon and FitzGibbon 1999). Information about the strains, including geographic origin and host, is listed in Table 1. The E. coli strain DH10B (F′−mcrA Δ(mrr-hsdRMS-mcrBC) φ80lacZΔM15 ΔlacX74 deoR recA1 endA1 araD139 Δ(ara, leu)7697 galU galK λ−rpsL nupG) (Invitrogen) and NM522 (supE, thi, Δ(lac-proAB), Δ hsd5 (r-,m-), F′ (proAB, lackqZ ΔM15) (Promega) were used as host strains for cloned bacteriocin genes. All Klebsiella and E. coli strains were cultured in Luria Broth (LB) (Sigma) at 37°C. LB medium was supplemented with ampicillin (100 μg/ml) for culturing the E. coli DH10B and E. coli NM522 containing Klebsiella genomic libraries.
Cloning and DNA Sequence Determination
Genomic and plasmid DNA were extracted using DNeasy Tissue kits (Qiagen) and Plasmid Miniprep kits (Qiagen). Cloning of the klebicin gene clusters was performed using standard protocols (Maniatis et al. 1982). Partially Sau3a1 restricted genomic DNA from Misc40 was cloned into the BamHI site of phagemid pBluescript II SK(+) (Strategene) and transformed into E. coli NM522 cells by electroporation. Partially restricted Tsp509I genomic DNA from Misc192 was cloned into the EcoRI site of phagemid pBluescript II SK(+) (Stratagene) and transformed into E. coli DH10B cells by electroporation. Transformants from both libraries were screened for bacteriocin production as described by Pugsley and Oudega (1987) using bacteriocin-sensitive strains Misc138 or Misc170, respectively, for screening the Misc40 or Misc192 libraries. Mitomycin C (0.5 μg/ml) was used to induce bacteriocin production in the transformants (Pugsley and Oudega 1987).
The cloned fragments encoding the klebicin killing activity (Misc40, klebicin C clone; and Misc192, klebicin D clone) were sequenced using Big Dye terminator in an ABI 377 DNA sequencer (Applied Biosystems) starting with the primers KS and SK located in the multiple cloning site of pBluescript SK(+) vector. Additional primers were designed to allow sequence walking through the cloned inserts. Double coverage was ensured by sequencing both strands of DNA. Sections of the bacteriocin gene cluster amplified by PCR from Klebsiella Misc712 were purified using QIA quick PCR purification Kit (Qiagen), and then sequenced as described above using the PCR primers.
PCR Screening
Klebsiella oxytoca Misc712 shared a similar killing spectrum as K. pneumoniae Misc40. This strain was screened for the presence of a klebicin gene cluster using PCR. Primers 5′-GCTCTGT AACCTTCAAGTTCTC-3′ and 5′-CAAGCAAGATTACGGTC TACTC-3′ yielded the expected 2.3-kb PCR product. PCR was performed using 1 unit of Taq polymerase (Promega) using standard PCR buffers. Annealing temperature of 54°C for 40 s and extension temperature of 72°C for 2 min were used for each of a total of 32 cycles.
Generation of Deletions in Klebicin Clones
A 4024-bp BsrGI fragment was deleted from the klebicin C clone to yield plasmid pBS-40r (Fig. 1a) using standard methods (Maniatis et al. 1982). A 768-bp EcoRI fragment, which includes 760 bases of the kdp gene, was deleted from the klebicin D clone to yield plasmid pBS-192 Δkdp (Fig. 1c). A 809-bp BsrGI fragment was deleted from the kda gene of klebicin D clone to yield a plasmid pBS-192Δkda (Fig. 1c). The deletions were confirmed by sequencing (data not shown). The resulting plasmids were electroporated into E. coli NM522 cells, grown in LB at 37°C with shaking, and bacteriocin production was induced by the addition of 0.5 μg/ml mitomycin C (Maniatis et al. 1982; Pugsley and Oudega 1987). Killing activity was assayed against the bacteriocin-sensitive strain Misc 170 or Misc138.
Klebicin clone organization. (a) Klebicin C clone from K. pneumoniae Misc40. (b) Klebicin C gene cluster from K. oxytoca Misc712. (c) Klebicin D clone from K. oxytoca Misc192. Promoter regions (↱), Lex A binding boxes (|), and similarity to each other ( ) and to known colicins E4 (▪), E1 (■), and D (
) and to known colicins E4 (▪), E1 (■), and D ( ) are indicated. The %AT composition over a 100-bp sliding window of klebicin C is represented below its genetic map. The Δkc-03–kc-09, Δkdp, and Δkda deletions are indicated by bold lines.
) are indicated. The %AT composition over a 100-bp sliding window of klebicin C is represented below its genetic map. The Δkc-03–kc-09, Δkdp, and Δkda deletions are indicated by bold lines.
DNA and Protein Sequence Analysis
The sequenced contigs were assembled using Sequencher 4.1 software (Gene Codes Corp.). The DNA sequences were queried against NCBI databases (NCBI: http://www.ncbi.nlm.nih.gov/BLAST/) using both nucleotide-BLAST (blastn) and translated-BLAST (tblastx) programs. Open reading frames (ORFs) were detected with software MapDraw (DNASTAR, Inc.) and the translated ORFs were searched using the blastp program against the NCBI databases. Bacteriocin activity proteins were aligned using the ClustalX algorithm in Megalign (DNASTAR, Inc.) and then converted back into DNA for subsequent phylogenetic analysis. A maximum parsimony tree was inferred using PAUP version 4.0b10 (Swofford 2002) and evaluated using 10,000 bootstrap replications. Kyte–Doolittle hydropathy plots of proteins were constructed using the software Protean 5.52 (DNASTAR, Inc.) using a sliding window of nine amino acids. The AT composition of the cloned sequences was evaluated using a sliding window of 100 bp.
Results
A previous survey of bacteriocin production in isolates of K. pneumoniae and K. oxytoca revealed two novel bacteriocin-like killing phenotypes. Genomic libraries of the two producing strains (Misc40 and 192) were created and screened for killing phenotypes. A single klebicin-producing clone containing a 9.0-kb insert (GenBank accession AY578793) was recovered from Misc40 and was referred to as the klebicin C clone. A single klebicin-producing clone containing a 6.5-kb insert (GenBank accession AY578792) was recovered from Miscl92 and was referred to as the klebicin D clone.
Klebicin C Clone
A 9.0-kb fragment containing the klebicin C killing activity was cloned from K. pneumoniae Misc40. The nucleotide sequence of the clone contains thirteen open reading frames (ORFs), all in the same transcriptional orientation (Fig. 1a and Table 2). Five of the ORFs are similar in sequence to bacteriophage genes (Table 2) including the ORFs; kc-01, which encodes a protein 72% identical to replication protein P of bacteriophage lambda (Sanger et al. 1982); kc-13, which encodes a protein 84% identical to prophage Fels1 antiterminator; and kcp, which encodes a protein 45% similar to tail fiber proteins of the Myoviridae bacteriophage family (Table 2). A deletion of ∼4 kb from the klebicin C clone, which includes kc-03 to kc-09 (Fig. 1a), did not affect the resulting killing phenotype. This deletion reveals that ORFs kc-03 to kc-09 do not play a role in bacteriocin-mediated killing.
Two colicin-like genes were identified in the klebicin C clone. The 1860-bp kca and 255-bp kci genes encode putative bacteriocin activity and immunity proteins, respectively (Fig. 1a and Table 2). These genes are found in the same transcriptional orientation, an arrangement typical of nuclease colicins. The encoded klebicin C activity protein (klebicin C) contains 619 amino acids with a deduced molecular mass of ∼66 kDa. The C-terminal 95 amino acids are 90% identical to the killing domain of colicin E4 (Fig. 1a), a member of the rRNase group of colicins, which kills by inhibiting protein synthesis through hydrolysis of 16S rRNA (Smarda et al. 1988). The remainder of the protein shows more limited sequence similarity with known bacteriocins. Residues 22–239 are 45% identical to the translocation domain of E1, which is a pore-forming colicin produced by Escherichia fergusonii that utilizes the TolCAQ translocation pathway (Lazdunski et al. 1998). The central region (residues 201–521) is 45% identical to the colicin D receptor-binding domain, which is a colicin produced by E. coli and known to bind to the FepA cell surface receptor (Braun 1995). However, this central region is most similar (63% sequence identity) to the corresponding region in klebicin D described below.
The klebicin C immunity protein contains 84 amino acids (molecular mass, ∼10 kDa) and shares 78% protein sequence identity with the colicin E4 immunity protein (Table 2). Two regions of the immunity protein (residues 6–20 and 51–73) harbor 17 of the 19 residues that differ from colicin E4. This same region segregates a significant number of differences when the immunity proteins of other rRNase colicins are compared. The elevated levels of divergence in these two restricted regions suggest they play a role in creating immunity specificity.
Colicin gene clusters are characteristically regulated by the SOS response and are thus repressed by the LexA repressor (Parker 1986; Riley et al. 2001; van den Elzen et al. 1982, 1983a). Riley et al. (2001) published an alignment of colicin promoters showing a dual overlapping LexA binding box between the Pribnow box and the start codon of most colicin genes. A similarly structured presumptive promoter containing the perfect palindrome, 5′ ATAACCAC TGTATAAATACACAGCTGTGTATTTATACA GTGGTTAT 3′, that includes two predicted LexA binding sites (underlined bases) was identified ∼1200 bp upstream of kca (Fig. 1a). This promoter appears to regulate the expression of an operon consisting of the phage-like kcp gene and the colicin-like kca and kci genes (Fig. 1a). A putative stem-loop transcriptional terminator (5′ AAATATAGCCAG CCTTCGTAGTTGGCTATATTT 3′) was identified downstream of kci.
A killing phenotype similar to that produced by K. pneumoniae Misc40 was detected in K. oxytoca Misc712. This prompted a PCR screen of Misc712 using primers designed from the klebicin C sequence. PCR products were sequenced and assembled to obtain a 2992-bp sequence (Fig. 1b; GenBank accession AY578794). The klebicin C gene cluster is highly conserved (99.7% identity) between these two producers, isolated from two different species, K. pneumoniae and K. oxytoca. Two nonsynonymous changes (amino acid replacements 255-Y to F and 366-K to N) were detected in the kcp gene. Three differences were detected in the kca gene: two nonsynonymous substitutions (116-L to Q and 260-K to M) and one synonymous substitution (position 1359). The immunity gene, kci, is identical between these strains. Four changes were detected in the 3′ flanking region (35,134, 224, and 255 bp downstream of the kci stop codon).
Klebicin D
A 6510-bp fragment containing the klebicin D killing activity was cloned from K. oxytoca Misc192. The nucleotide sequence of the clone revealed five ORFs, three of which form a putative bacteriocin operon (Fig. 1c and Table 3). The klebicin D operon consists of kdp (1134-bp homologue of the bacteriophage-like kcp gene identified in the klebicin C operon), kda (2151-bp putative bacteriocin activity gene), and kdi (267-bp putative immunity gene). kdp encodes a protein 70% identical to that encoded by kcp and 43% similar to the C-terminal domain of the phage tail protein of bacteriophage K3 (Fig. 1 and Table 3). Deletion of 760 bp of the kdp gene (Fig. 1c) results in loss of killing activity, suggesting that this protein is required for kda-encoded toxin activity.
The encoded klebicin D protein contains 716 amino acids with a molecular mass of ∼76 kDa. The C-terminal 91 amino acids are 85% identical to the corresponding region in colicin D, which is produced by E. coli and functions by hydrolyzing arginine tRNA to inhibit protein synthesis (Masaki and Ogawa 2002; Tomita et al. 2000) (Fig. 1c). This suggests that klebicin D is a member of the tRNase group of bacteriocins that includes colicins D and E5 (Hofinger et al. 1998; Masaki et al. 1997; Roos et al. 1989). The receptor-binding domain of klebicin D (residues 301–613) is most similar to the corresponding region of klebicin C (63% sequence identity) (Fig. 1). More limited similarity (45%) is detected to the colicin D receptor region. The N-terminal translocation domain is unique. Deletion of the 809 bp of the kda gene (Fig. 1c) results in loss of killing activity, suggesting that kda is responsible for the killing phenotype.
The immunity gene, kdi, is located downstream of kda in the same transcriptional orientation, as observed in klebicin C and other nuclease colicin operons. It encodes an 88-amino acid protein (molecular mass, ∼10 kDa) that is 59% identical to the colicin D immunity protein. A total of 35 amino acid replacements distributed over the length of protein were observed between the immunity proteins of klebicin D and colicin D.
The operon structure of klebicin D is similar to that determined for klebicin C (Fig. 1c). The kda start codon is 80 bases downstream of the kdp stop codon, while kdi overlaps kda by 4 bp. Expression of this gene cluster appears to be controlled by an SOS regulated promoter identified upstream of kdp. Unlike the dual overlapping LexA sites found in klebicin C and most colicin operons, the klebicin D operator appears to contain only a single LexA binding site (5′ TACTGTATGTATATACAGTA 3′) that matches the bacterial LexA binding site consensus sequence 5′ TACTG(TA)5CAGTA 3′ (Walker 1984) more closely than any other colicin promoters (Riley et al. 2001). The observation that klebicin D expression is induced by mitomycin C (data not shown) further suggests that the LexA binding site controls klebicin expression. A second putative promoter was identified upstream of kdi and is presumed to be a constitutive promoter that ensures low-level-immunity protein production to protect the cell from klebicin D activity (Chak and James 1984, 1985; Cole et al. 1985). A putative stem-loop transcription terminator sequence (5′ TAGCCAACCTCTCGGGTTGGCTA 3′) was identified 26 bp downstream of the kdi stop codon.
Discussion
The focus of this study is the molecular characterization of two novel klebicin gene clusters and an investigation into the evolutionary mechanisms responsible for generating klebicin diversity. To date, only two bacteriocins from Klebsiella have been sequenced, klebicins B (Riley et al. 2001) and CCL (NCBI accession AF190857). The klebicin B operon is a chimera, composed of short regions each with a different evolutionary origin (Riley et al. 2001). The encoded killing domain is most similar to the corresponding region in pyocin S1, a DNase bacteriocin produced by Pseudomonas aeruginosa. The receptor-binding and translocation regions are unique. The lysis gene and flanking regions are most similar to those found in colicin A, a pore-forming bacteriocin produced by Citrobacter freundii (Riley et al. 2001). The resulting chimeric klebicin B operon encodes two functions (killing and lysis) found in multiple species (killing, P. aeruginosa and K. pneumoniae; lysis, C. freundii and K. pneumoniae) and two functions found only in Klebsiella (unique receptor recognition and translocation functions), which presumably serve to restrict bacteriocin activity to close relatives of the producing strains.
In sharp contrast, the entire klebicin CCL operon is nearly identical (99%) to that of cloacin DF13, which encodes a nuclease bacteriocin produced by Enterobacter cloacae. Cloacin DF13 utilizes the TolABQR pathway for translocation and employs IutA as a cell surface receptor (Cooper and James 1985; James et al. 1987). The near-identity of the translocation and receptor binding domains in DF13 and klebicin CCL suggests that the Tol pathway and the IutA receptor are shared between these species. Indeed, the partially completed K. pneumoniae genome sequence (Washington University in St. Louis Genome Sequencing Center; http://genome.wustl. edu) encodes an IutA protein that is 99% identical in sequence to that identified from E. coli. Further, this same receptor is present in most enteric species, suggesting that a bacteriocin targeting such a receptor would have a relatively broad killing breadth. A partial sequence of a putative to 1ABQR gene cluster was identified in the K. pneumoniae partial genome sequence, which is 81% identical to the tolA gene identified from E. coli. The tolABQR genes are found in most species of enteric bacteria, suggesting the presence of a common mode of entry for colicins and colicin-like bacteriocins.
We describe here the sequence and genetic structure of two novel klebicins, C and D. Klebicin C is predicted to be a member of the rRNase bacteriocin group (based on protein sequence similarity) and is produced by both K. pneumoniae and K. oxytoca. Klebicin D has been found only in K. pneumoniae and is predicted to be a member of the tRNase bacteriocin group. Sequence analysis reveals that both klebicins are expressed as SOS-regulated transcriptional units consisting of three genes: kcp, kca, and kci in klebicin C and kdp, kda, and kdi in klebicin D. The kca/kda and kci/kdi genes encode the bacteriocin activity and immunity proteins, respectively. The kcp/kdp genes are similar in sequence (70% identity) and encode a protein similar (∼45%) to a family of phage tail fiber-like proteins (Miller et al. 2003; Riede et al. 1986). Although the specific function of the kcp/kdp genes is unknown, our preliminary evidence (consisting of deletion analysis) suggests that this gene or gene product is required for klebicin production and/or activity. Such an operon structure, with an additional bacteriophage-related gene inserted between the bacteriocin promoter and the toxin-related genes, has not previously been described in the literature.
The four characterized klebicin proteins (B, C, D, and CCL) all appear to share a three-domain structure typical of colicin proteins, with an N-terminal translocation domain, a central receptor binding domain, and a C-terminal killing domain. In the case of klebicin C, the three domains appear to be a composite of sequences found in at least three other bacteriocins (Fig. 1a). The N-terminal translocation domain is similar to the corresponding region of colicin E1, which employs the Tol system to translocate into the target cell (Lazdunski et al. 1998). The highest level of similarity is found in the TolC domain of colicins E1, 5, and 10, suggesting that TolC may be required for translocation of klebicin C (Pilsl and Braun 1995). A protein with 84% identity to the TolC protein of E. coli was found in the partially complete K. pneumoniae genome sequence (Washington University in St. Louis Genome Sequencing Center; http://genome.wustl.edu), which further supports the proposed role of TolC in klebicin C translocation. The klebicin C receptor recognition region is most similar to the corresponding region in klebicin D, which is unique to these two klebicins. The killing domain of klebicin C is homologous to the corresponding region in rRNase colicins, which function by inhibiting protein synthesis by hydrolyzing 16S rRNA (Smarda et al. 1988). Bacteriocins belonging to rRNase group include E3, E4, and E6 (produced by E. coli), cloacin DF13 (produced by E. cloacae), and klebicins CCL and C (produced by K. pneumoniae). In summary, klebicin C appears to have evolved from multiple recombination events resulting in a chimeric protein consisting of a novel translocation domain fused to a colicin E1-like TolC box, a klebicin D-like receptor binding domain, and a colicin E4-like rRNase killing domain.
The klebicin C operon is highly conserved in two Klebsiella isolates (K. pneumoniae Misc40 and K. oxytoca Misc712), which were identified with identical killing profiles (Riley et al. 2003). These strains were isolated from different hosts (Mus musculus and Chalinolobus gouldii) and from widely separated geographic regions (Victoria and New South Wales) (Table 1). The near-identity of these two bacteriocin operons (only 9 substitutions in 2977 bp) recovered from two species of Klebsiella, and from such disparate mammalian hosts and location, suggests both a recent common ancestry and rapid spread of the bacteriocin.
The partial ORFs flanking the klebicin C operon are similar to the P and Q genes of lambdoid bacteriophage. In phage the region between P and Q can be deleted or replaced while maintaining phage viability. For example, lambdoid phages harboring shiga toxins in this segment have been described (Karch et al. 1999). The klebicin C operon (composed of ∼50% G and C) appears to have been inserted into the P and Q regions of an existing prophage (∼50% GC). In addition, an AT-rich region (35% GC) extending from kc-06 to kc-09 (Fig. 1a) suggests that this segment may have been acquired via a separate horizontal transfer event. One gene in this segment, kc-07, is similar to RTX toxins (Table 2).
Klebicin D belongs to a small family of tRNase bacteriocins, which kill by hydrolyzing specific tRNAs. This family consists of only two additional members, colicins D and E5, which differ with respect to the tRNA species hydrolyzed. Klebicin D is more closely related to colicin D, which targets arginine tRNA (Masaki and Ogawa 2002). Colicin D is processed within the target cell by peptidase to release its tRNase activity (de Zamaroczy et al. 2001). The colicin D processing site is proposed to reside between residues 571 and 606 (de Zamaroczy et al. 2001). This region is highly conserved (92% similarity) between colicin D and klebicin D, suggesting that klebicin D undergoes similar processing. The receptor-binding domain of klebicin D is most closely related to that of klebicin C and its translocation domain is unique. Thus, klebicin D is also a chimeric protein, with a killing domain derived from a nuclease colicin ancestor (such as colicin D), a receptor recognition domain derived from a klebicin C-like ancestor and a unique translocation domain.
Most colicin and colicin-like gene clusters contain a closely linked lysis gene, which encodes a protein involved in the release of colicins from the producer cell (Pugsley and Schwartz 1983b; Riley and Wertz 2002). It is absent from some pore-forming colicin gene clusters, such as colicin B (Pressler et al. 1986) and Ib (Mankovich et al. 1986), but is always found within 100 bp 3′ to the immunity gene in nuclease bacteriocin gene clusters, including klebicins B and CCL of K. pneumoniae. No identifiable lysis gene was detected within 400 bp downstream of the immunity genes in the klebicin C and D operons. The identification of putative transcriptional terminators immediately downstream of kci and kdi and the killing activity of the cloned insert suggests that there is no lysis gene associated with this operon. If so, klebicins C and D are the first colicin-like nuclease bacteriocin operons that lack an identifiable lysis gene.
Deletion analysis revealed that kdp, and presumably also kcp, is required for klebicin activity. Hydropathy plots and predicted secondary structures were compared between the kcp and kdp encoded proteins and those of representative colicin lysis proteins. No similarities, in terms of predicted structure or even hydrophilic tendencies, were detected. This suggests that, if kcp and kdp encode proteins involved in klebicin release, they do so in a manner quite different from traditional colicin lysis proteins. In Serratia marcescens, a phage holin-like protein has been proposed to release marcesin 28B, a chromosomally encoded bacteriocin (Ferrer et al. 1996).
Klebicin gene clusters show several similarities to colicin operons. As is consistently found for nuclease colicins, klebicin C and D gene clusters have activity and immunity genes encoded on the same strand of DNA (Braun et al. 1994). This arrangement differs from that found in the pore-forming colicins, which encode the colicin and immunity genes in the opposite transcriptional orientation (Braun et al. 1994). The regulatory organization of the klebicin C and D operons is similar to that observed in colicins. Both klebicin operons are expressed from an SOS-regulated promoter with LexA binding sites located downstream of a −10 promoter. A sequence downstream of the immunity genes that forms a potential stem-loop may serve as the transcriptional terminator for both of these operons. An additional promoter detected upstream of the immunity genes appears to ensure constitutive expression of the immunity protein to protect the cells from their cognate klebicins. Such SOS-independent expression of immunity genes is a general feature of nuclease colicin operons (Chak and James 1984, 1985; Cole et al. 1985). The klebicin C operator has two overlapping LexA binding sites, typical of most colicin operators, including colicins A, B, D, E1, E2, E3, E6, K, N, S4, U, Y, 5, 10, klebicin B, and pesticin (Riley et al. 2001; van den Elzen et al. 1982). Klebicin D has a single LexA binding site, as is found in cloacin DF13 (van den Elzen et al. 1983b), klebicin CCL (NCBI AF190857), marcescin A (unpublished result), and colicins Ia and Ib (Fernandez De Henestrosa et al. 2000).
Klebicins B, C, D, and CCL are predicted to function as nucleases. Figure 2 provides a phylogenetic tree inferred for nuclease killing domains. Three highly divergent lineages corresponding to the DNase, rRNase, and tRNase functional groups of nuclease bacteriocins are distinguished. Klebicins are represented in all three groups: the DNase family (klebicin B), the tRNase family (klebicin D), and the rRNase family (klebicins C and CCL).
It has been demonstrated that many colicins and colicin-like bacteriocins evolve by recombination between existing colicin gene clusters, resulting in novel arrangements of colicin functional domains (such as found in colicins B and D) or in different combinations of colicin, immunity, and lysis genes (such as found in colicins K, 5, and 10) (Braun et al. 1994; Riley 1998; Riley and Wertz 2002). Not surprisingly, klebicins C and D follow this general pattern of recombination-mediated diversification. Each bacteriocin toxin and bacteriocin operon is composed of regions derived from several different putative ancestral sequences.
A second process of diversification has been implicated in nuclease bacteriocin evolution, which involves diversifying selection acting on the immunity protein and the immunity binding region of the cognate bacteriocin (Riley 1993a, 1998; Riley and Wertz 2002). Studies of the levels and patterns of DNA sequence polymorphism and divergence among nuclease colicin operons have suggested that immunity proteins and the immunity binding regions of their cognate bacteriocins segregate similarly high levels of nucleotide diversity, relative to the remainder of the gene cluster (Riley 1993a, b). These data, combined with experimental evolution studies (Tan and Riley 1997), have been interpreted to suggest that nuclease colicins experience strong diversifying selection acting on novel immunity specificities created by point mutations (Riley and Wertz 2002).
Table 4 provides an estimate of the nucleotide divergence observed between klebicin C and its closest rRNase bacteriocins (cloacin DF13, klebicin CCL, colicins E3, E4, and E6) and klebicin D and its closest tRNase bacteriocin (colicin D). Levels of synonymous substitutions are nearly equal when compared between the regions encoding the bacteriocin killing and immunity functions. In contrast, twice as many nonsynonymous substitutions have accumulated in the region encoding immunity function compared to the region encoding killing function. This pattern of substitution is quite different from that observed among nuclease colicins experiencing diversifying selections, which suggests that a different sort of evolutionary force may be acting on klebicins. Unfortunately, the high levels of recombination detected in klebicin operons preclude analyses aimed at determined whether these operons are experiencing selection.
The klebicin operons described here suggest a third mechanism for bacteriocin diversification, which involves recruiting an additional protein, a phage tail fiber-like protein, within the bacteriocin operon. Phage tail fiber proteins function in contact initiation and binding of the bacteriophage to its target bacterial host (Hendrix et al. 1999, 2003; Tetart et al. 1998). Host specificity is attributed to the variable C-terminal domain of the tail fiber, which can be swapped between different phages (Tetart et al. 1998).
The proteins encoded by kcp and kdp are similar to the C-terminal domain of several tail fiber proteins, whose functions are equivalent to those provided by the receptor binding domains of colicins. It is possible that klebicins have recruited binding proteins from bacteriophage, in addition to tapping into the existing pool of shared colicin functional domains. Figure 3 illustrates a hypothetical process, involving bacteriocin and bacteriophage interactions, which would result in the observed klebicin C and D operons. The first step in this process proposes a recombination event between a hypothetical colicin D-like ancestral bacteriocin and a Myoviridae-like bacteriophage ancestor resulting in insertion of a phage tail fiber-like protein between the bacteriocin promoter and the activity gene. Subsequent acquisition of a novel translocation domain results in a klebicin D-like bacteriocin. An alternative path involves duplication of the LexA binding site in the bacteriocin promoter region and acquisition of novel killing and translocation domains, resulting in a klebicin C-like bacteriocin.
Not shown in this scenario is the insertion of the entire bacteriocin gene cluster into an existing prophage. The presence of phage-like P and Q genes in the klebicin C operon further supports this hypothesized unique role bacteriophage may play in the evolution of klebicins. The klebicin C operon is straddled by sequences known to reside in prophage. Such genetic elements are mobile and could carry the encoded bacteriocin to new bacterial hosts, as is observed for klebicin C, which was found in Misc40 and Misc712 belonging to K. pneumoniae and K. oxytoca, respectively.
References
V Braun (1995) ArticleTitleEnergy-coupled transport and signal transduction through the gram-negative outer membrane via TonB-ExbB-ExbD-dependent receptor proteins FEMS Microbiol Rev 16 295–307 Occurrence Handle10.1016/0168-6445(95)00003-U Occurrence Handle1:CAS:528:DyaK2MXntFCrsLc%3D Occurrence Handle7654405
V Braun H Pilsl P Gross (1994) ArticleTitleColicins: structures, modes of action, transfer through membranes, and evolution Arch Microbiol 161 199–206 Occurrence Handle1:STN:280:ByuB3Mzls10%3D Occurrence Handle8161282
KF Chak R James (1984) ArticleTitleLocalization and characterization of a gene on the ColE3-CA38 plasmid that confers immunity to colicin E8 J Gen Microbiol 130 701–710 Occurrence Handle1:CAS:528:DyaL2cXltVCqtb0%3D Occurrence Handle6327884
KF Chak R James (1985) ArticleTitleAnalysis of the promoters for the two immunity genes present in the ColE3-CA38 plasmid using two new promoter probe vectors Nucleic Acids Res 13 2519–2531 Occurrence Handle1:CAS:528:DyaL2MXhvFyktLY%3D Occurrence Handle2987857
ST Cole B Saint-Joanis AP Pugsley (1985) ArticleTitleMolecular characterisation of the colicin E2 operon and identification of its products Mol Gen Genet 198 465–472 Occurrence Handle10.1007/BF00332940 Occurrence Handle1:CAS:528:DyaL2MXktlarsr4%3D Occurrence Handle3892228
PC Cooper R James (1985) ArticleTitleThree immunity types of klebicins which use the cloacin DF13 receptor of Klebsiella pneumoniae J Gen Microbiol 131 2313–2318 Occurrence Handle1:CAS:528:DyaL2MXmtFSms7k%3D Occurrence Handle3906039
AR De Fernandez Henestrosa T Ogi S Aoyagi D Chafin JJ Hayes H Ohmori R Woodgate (2000) ArticleTitleIdentification of additional genes belonging to the LexA regulon in Escherichia coli Mol Microbiol 35 1560–1572 Occurrence Handle10.1046/j.1365-2958.2000.01826.x Occurrence Handle10760155
M Zamaroczy Particlede L Mora A Lecuyer V Geli RH Buckingham (2001) ArticleTitleCleavage of colicin D is necessary for cell killing and requires the inner membrane peptidase LepB. Mol Cell 8 159–168 Occurrence Handle10.1016/S1097-2765(01)00276-3
S Ferrer MB Viejo JF Guasch J Enfedaque M Regue (1996) ArticleTitleGenetic evidence for an activator required for induction of colicin-like bacteriocin 28b production in Serratia marcescens by DNA-damaging agents J Bacteriol 178 951–960 Occurrence Handle1:CAS:528:DyaK28XpvVaitQ%3D%3D Occurrence Handle8576068
DM Gordon F FitzGibbon (1999) ArticleTitleThe distribution of enteric bacteria from Australian mammals: host and geographical effects Microbiology 145 2663–2671 Occurrence Handle1:CAS:528:DyaK1MXmvVahtLc%3D Occurrence Handle10537188
JF Guasch J Enfedaque S Ferrer D Gargallo M Regue (1995) ArticleTitleBacteriocin 28b, a chromosomally encoded bacteriocin produced by most Serratia marcescens biotypes Res Microbiol 146 477–483 Occurrence Handle10.1016/0923-2508(96)80293-2 Occurrence Handle1:CAS:528:DyaK2MXotVajtL0%3D Occurrence Handle8525064
RW Hendrix MC Smith RN Burns ME Ford GF Hatfull (1999) ArticleTitleEvolutionary relationships among diverse bacteriophages and prophages: all the world’s a phage Proc Natl Acad Sci USA 96 2192–2197 Occurrence Handle10.1073/pnas.96.5.2192 Occurrence Handle1:CAS:528:DyaK1MXhvVSqsbg%3D Occurrence Handle10051617
RW Hendrix GF Hatfull MC Smith (2003) ArticleTitleBacteriophages with tails: chasing their origins and evolution Res Microbiol 154 253–257 Occurrence Handle10.1016/S0923-2508(03)00068-8 Occurrence Handle1:CAS:528:DC%2BD3sXkt1ymur8%3D Occurrence Handle12798229
C Hofinger H Karch H Schmidt (1998) ArticleTitleStructure and function of plasmid pCo1D157 of enterohemorrhagic Escherichia coli O157 and its distribution among strains from patients with diarrhea and hemolytic-uremic syndrome J Clin Microbiol 36 24–29 Occurrence Handle1:CAS:528:DyaK1cXjtVeitw%3D%3D Occurrence Handle9431914
R James J Schneider PC Cooper (1987) ArticleTitleCharacterization of three group A klebicin plasmids: localization of their E colicin immunity genes J Gen Microbiol 133 2253–2262 Occurrence Handle1:CAS:528:DyaL2sXlsVyhsLs%3D Occurrence Handle3127541
H Karch H Schmidt C Janetzki-Mittmann J Scheef M Kroger (1999) ArticleTitleShiga toxins even when different are encoded at identical positions in the genomes of related temperate bacteriophages Mol Gen Genet 262 600–607 Occurrence Handle10.1007/s004380051122 Occurrence Handle1:CAS:528:DC%2BD3cXmvFKlsQ%3D%3D Occurrence Handle10628842
S Karlin J Mrazek AM Campbell (1998) ArticleTitleCodon usages in different gene classes of the Escherichia coli genome Mol Microbiol 29 1341–1355 Occurrence Handle10.1046/j.1365-2958.1998.01008.x Occurrence Handle1:CAS:528:DyaK1cXmsVKisLc%3D Occurrence Handle9781873
B Korber (2000) HIV signature and sequence variation analysis AG Rodrigo GH Learn (Eds) Computational analysis of HIV moleoular sequences Kluwer Academic Dordrecht, Netherlands 55–72
CJ Lazdunski E Bouveret A Rigal L Journet R Lloubes H Benedetti (1998) ArticleTitleColicin import into Escherichia coli cells J Bacteriol 180 4993–5002 Occurrence Handle1:CAS:528:DyaK1cXms1eiu7Y%3D Occurrence Handle9748429
T Maniatis EF Fritsch J Sambrook (1982) Molecular cloning: A laboratory manual Cold Spring Harbor Laboratory Cold Spring Harbor, NY
JA Mankovich CH Hsu J Konisky (1986) ArticleTitleDNA and amino acid sequence analysis of structural and immunity genes of colicins Ia and Ib J Bacteriol 168 228–236 Occurrence Handle1:CAS:528:DyaL2sXhtFak Occurrence Handle3531169
H Masaki T Ogawa (2002) ArticleTitleThe modes of action of colicins E5 and D, and related cytotoxic tRNases Biochimie 84 433–438 Occurrence Handle10.1016/S0300-9084(02)01425-6 Occurrence Handle1:CAS:528:DC%2BD38XosFersL8%3D Occurrence Handle12423786
Masaki H, Ogawa T, Tomita K, Ueda T, Watanabe K, Uozumi T (1997) Colicin E5 as a new type of cytotoxin, which cleaves a specific group of tRNAs. Nucleic Acids Symp Ser 287–288
ES Miller JF Heidelberg JA Eisen WC Nelson AS Durkin A Ciecko TV Feldblyum O White IT Paulsen WC Nierman J Lee B Szczypinski CM Fraser (2003) ArticleTitleComplete genome sequence of the broad-host-range vibriophage KVP40: comparative genomics of a T4-related bacteriophage J Bacteriol 185 5220–5233 Occurrence Handle10.1128/JB.185.17.5220-5233.2003 Occurrence Handle1:CAS:528:DC%2BD3sXmvVersb4%3D Occurrence Handle12923095
M Nasu (1981) ArticleTitleEpidemiological studies of Serratia marcescens infections by bacteriocin (marcescin) typing Tohoku J Exp Med 133 45–52 Occurrence Handle1:STN:280:Bi6B3c7lslE%3D
M Nei T Gojobori (1986) ArticleTitleSimple methods for estimating the numbers of synonymous and nonsynonymous nucleotide substitutions Mol Biol Evol 3 418–426 Occurrence Handle1:CAS:528:DyaL28Xmt1aisbs%3D Occurrence Handle3444411
RC Parker (1986) ArticleTitleMitomycin C-induced bidirectional transcription from the colicin E1 promoter region in plasmid ColE1 Biochim Biophys Acta 868 39–44 Occurrence Handle1:CAS:528:DyaL28XmtF2ku7k%3D Occurrence Handle3092859
H Pilsl V Braun (1995) ArticleTitleNovel colicin 10: assignment of four domains to TonB- and TolC-dependent uptake via the Tsx receptor and to pore formation Mol Microbiol 16 57–67 Occurrence Handle1:CAS:528:DyaK2MXlt1agsbg%3D Occurrence Handle7651137
U Pressler V Braun B Wittmann-Liebold R Benz (1986) ArticleTitleStructural and functional properties of colicin B J Biol Chem 261 2654–2659 Occurrence Handle1:CAS:528:DyaL28Xht1Ggsbk%3D Occurrence Handle2419320
AP Pugsley B Oudega (1987) Methods for studying colicins and their plasmids IRL Press Oxford
AP Pugsley M Schwartz (1983a) ArticleTitleExpression of a gene in a 400-base-pair fragment of colicin plasmid ColE2-P9 is sufficient to cause host cell lysis J Bacteriol 156 109–114 Occurrence Handle1:CAS:528:DyaL3sXmtVOitL0%3D
AP Pugsley M Schwartz (1983b) ArticleTitleA genetic approach to the study of mitomycin-induced lysis of Escherichia coli K-12 strains which produce colicin E2 Mol Gen Genet 190 366–372 Occurrence Handle10.1007/BF00331060 Occurrence Handle1:CAS:528:DyaL3sXltFKqsL8%3D
A Rakin E Boolgakowa J Heesemann (1996) ArticleTitleStructural and functional organization of the Yersinia pestis bacteriocin pesticin gene cluster Microbiology 142 3415–3424 Occurrence Handle1:CAS:528:DyaK2sXkt1eisg%3D%3D Occurrence Handle9004504
I Riede K Drexler ML Eschbach U Henning (1986) ArticleTitleDNA sequence of the tail fiber genes 37, encoding the receptor recognizing part of the fiber, of bacteriophages T2 and K3 J Mol Biol 191 255–266 Occurrence Handle10.1016/0022-2836(86)90262-7 Occurrence Handle1:CAS:528:DyaL2sXhtFah Occurrence Handle3806672
MA Riley (1993a) ArticleTitleMolecular mechanisms of colicin evolution Mol Biol Evol 10 1380–1395 Occurrence Handle1:CAS:528:DyaK2cXisFSmsw%3D%3D
MA Riley (1993b) ArticleTitlePositive selection for colicin diversity in bacteria Mol Biol Evol 10 1048–1059 Occurrence Handle1:CAS:528:DyaK3sXmsVGnsro%3D
MA Riley (1998) ArticleTitleMolecular mechanisms of bacteriocin evolution Annu Rev Genet 32 255–278 Occurrence Handle10.1146/annurev.genet.32.1.255 Occurrence Handle1:CAS:528:DyaK1MXjvFWlsA%3D%3D Occurrence Handle9928481
MA Riley JE Wertz (2002) ArticleTitleBacteriocins: evolution, ecology, and application Annu Rev Microbiol 56 117–137 Occurrence Handle10.1146/annurev.micro.56.012302.161024 Occurrence Handle1:CAS:528:DC%2BD38Xos1Gis78%3D Occurrence Handle12142491
MA Riley T Pinou JE Wertz Y Tan CM Valletta (2001) ArticleTitleMolecular characterization of the klebicin B plasmid of Klebsiella pneumoniae Plasmid 45 209–221 Occurrence Handle10.1006/plas.2001.1519 Occurrence Handle1:CAS:528:DC%2BD3MXktlaksL8%3D Occurrence Handle11407916
MA Riley CM Goldstone JE Wertz D Gordon (2003) ArticleTitleA phylogenetic approach to assessing the targets of microbial warfare J Evol Biol 16 690–697 Occurrence Handle10.1046/j.1420-9101.2003.00575.x Occurrence Handle1:STN:280:DC%2BD3srlt1Glsw%3D%3D Occurrence Handle14632232
U Roos RE Harkness V Braun (1989) ArticleTitleAssembly of colicin genes from a few DNA fragments Nucleotide sequence of colicin D. Mol Microbiol 3 891–902 Occurrence Handle1:CAS:528:DyaK3cXhvFaktrg%3D
F Sanger AR Coulson GF Hong DF Hill GB Petersen (1982) ArticleTitleNucleotide sequence of bacteriophage lambda DNA J Mol Biol 162 729–773 Occurrence Handle10.1016/0022-2836(82)90546-0 Occurrence Handle1:CAS:528:DyaL3sXitFSksrw%3D Occurrence Handle6221115
J Smarda P Uher P Osecky (1988) ArticleTitleModes of action of colicins E4-E7: rates of basic biosyntheses inhibition Zentralbl Bakteriol Mikrobiol Hyg [A] 269 7–14 Occurrence Handle1:CAS:528:DyaL1cXmtVyit7Y%3D
Swofford DL (2002) PAUP*: Phylogenetic Analysis Using Parsimony (and Other Methods), version 4.0 Beta
JR Tagg AS Dajani LW Wannamaker (1976) ArticleTitleBacteriocins of gram-positive bacteria Bacteriol Rev 40 722–756 Occurrence Handle1:CAS:528:DyaE28Xlsleru78%3D Occurrence Handle791239
Y Tan MA Riley (1997) ArticleTitleNucleotide polymorphism in colicin E2 gene clusters: evidence for nonneutral evolution Mol Biol Evol 14 666–673 Occurrence Handle1:CAS:528:DyaK2sXjsVGhtLw%3D Occurrence Handle9190068
F Tetart C Desplats HM Krisch (1998) ArticleTitleGenome plasticity in the distal tail fiber locus of the T-even bacteriophage: recombination between conserved motifs swaps adhesin specificity J Mol Biol 282 543–556 Occurrence Handle10.1006/jmbi.1998.2047 Occurrence Handle1:CAS:528:DyaK1cXmtlyhtrs%3D Occurrence Handle9737921
GA Tieze AH Stouthamer HS Jansz J Zandberg EFJ Bruggen Particlevan (1969) ArticleTitleA bacteriocinogenic factor of Enterobacter cloacae Mol Gen Genet 106 48–65 Occurrence Handle10.1007/BF00332820 Occurrence Handle1:CAS:528:DyaE3cXktFWls7o%3D Occurrence Handle4905439
K Tomita T Ogawa T Uozumi K Watanabe H Masaki (2000) ArticleTitleA cytotoxic ribonuclease which specifically cleaves four isoaccepting arginine tRNAs at their anticodon loops Proc Natl Acad Sci USA 97 8278–8283 Occurrence Handle10.1073/pnas.140213797 Occurrence Handle1:CAS:528:DC%2BD3cXlt1Ggt7Y%3D Occurrence Handle10880568
WH Traub EA Raymond Startsmar TS (1971) ArticleTitleBacteriocin (Marcescin) typing of clinical isolates of Serratia marcescens Appl Microbiol 21 837–840 Occurrence Handle1:STN:280:CS6C1crltV0%3D Occurrence Handle4930037
PJ van den Elzen MJ Hakkaart AJ van Putten HH Walters E Veltkamp HJ Nijkamp (1983a) ArticleTitleStructure and regulation of gene expression of a Clo DF13 plasmid DNA region involved in plasmid segregation and incompatibility Nucleic Acids Res 11 8791–8808 Occurrence Handle1:CAS:528:DyaL2cXhtFGlsr8%3D
PJ van den Elzen J Maat HH Walters E Veltkamp HJ Nijkamp (1982) ArticleTitleThe nucleotide sequence of the bacteriocin promoters of plasmids Clo DF13 and Col E1: role of lexA repressor and cAMP in the regulation of promoter activity Nucleic Acids Res 10 1913–1928 Occurrence Handle1:CAS:528:DyaL38XhvFChsr8%3D Occurrence Handle6281726
PJ van den Elzen HH Walters E Veltkamp HJ Nijkamp (1983b) ArticleTitleMolecular structure and function of the bacteriocin gene and bacteriocin protein of plasmid Clo DF13 Nucleic Acids Res 11 2465–2477 Occurrence Handle1:CAS:528:DyaL3sXktFOgtrw%3D
MB Viejo D Gargallo S Ferrer J Enfedaque M Regue (1992) ArticleTitleCloning and DNA sequence analysis of a bacteriocin gene of Serratia marcescens J Gen Microbiol 138 1737–1743 Occurrence Handle1:CAS:528:DyaK3sXksVahtbY%3D Occurrence Handle1527512
GC Walker (1984) ArticleTitleMutagenesis and inducible responses to deoxyribonucleic acid damage in Escherichia coli Microbiol Rev 48 60–93 Occurrence Handle1:CAS:528:DyaL2cXhslWhsL4%3D Occurrence Handle6371470
JE Wertz MA Riley (2004) ArticleTitleChimeric Nature of two plasmids of Hafinia alvei encoding the bacteriocins alveicins A and B J Bacteriol 186 1598–1605 Occurrence Handle10.1128/JB.186.6.1598-1605.2004 Occurrence Handle1:CAS:528:DC%2BD2cXitlGhs74%3D Occurrence Handle14996789
Acknowledgments
We are grateful to David Gordon (Department of Botany and Zoology, Australia National University, Canberra) for providing all of the natural isolates used in this study. We acknowledge Lisa Nigro and Cynthia Winkworth for their contributions to the sequencing of the klebicin clones. This material is based on work supported by the National Institutes of Health (M.A.R., Grant GM58433-02) as well as the National Science Foundation (J.E.W).
Author information
Authors and Affiliations
Corresponding author
Additional information
Reviewing Editor: Prof. David Guttman
Rights and permissions
About this article
Cite this article
Chavan, M., Rafi, H., Wertz, J. et al. Phage Associated Bacteriocins Reveal a Novel Mechanism for Bacteriocin Diversification in Klebsiella. J Mol Evol 60, 546–556 (2005). https://doi.org/10.1007/s00239-004-0263-9
Received:
Accepted:
Issue Date:
DOI: https://doi.org/10.1007/s00239-004-0263-9

).
).